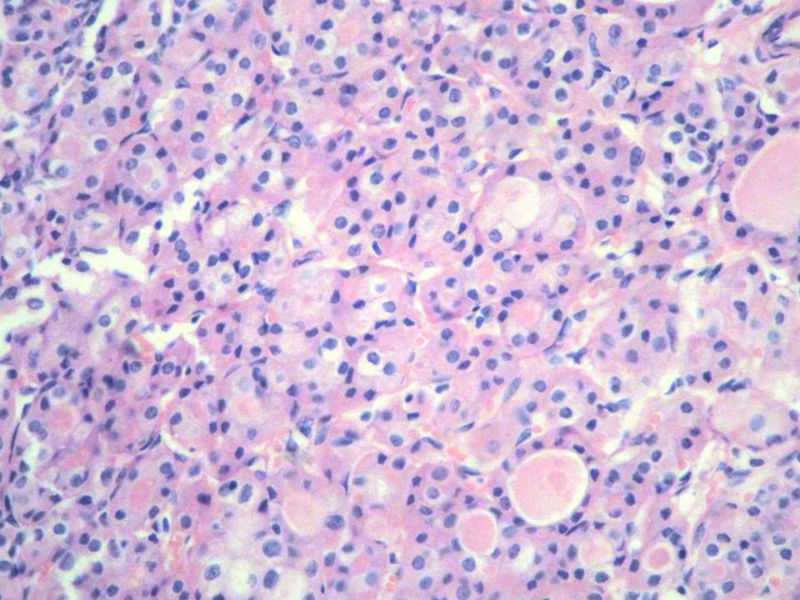
右侧甲状腺肿物图11
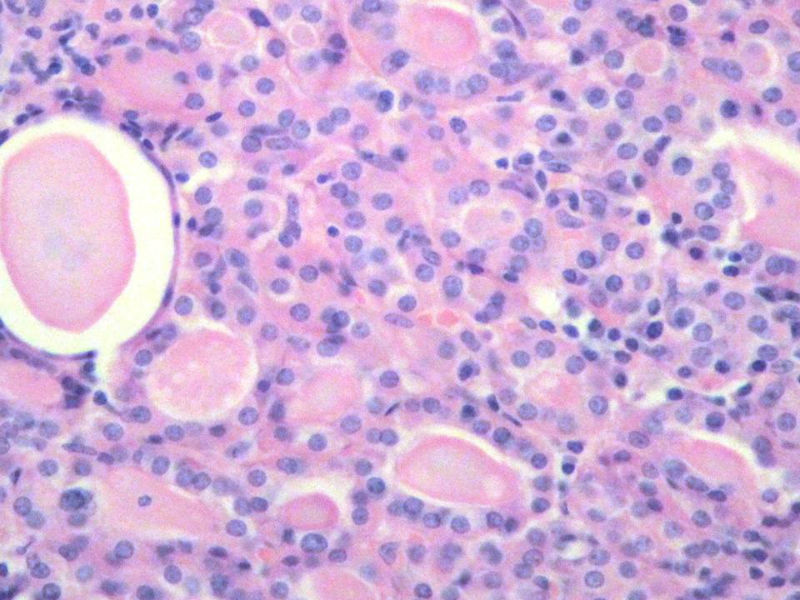
右侧甲状腺肿物图12

| 图片: | |
|---|---|
| 名称: | |
| 描述: | |
- 右侧甲状腺肿物
女,60岁,右侧甲状腺肿物两个月,术中见肿块与周围组织无粘连,肉眼,灰红色组织,3X2X2厘米,切面见一直径2.5厘米肿物,包膜完整,灰黄色,质软。

名称:图1
描述:幻灯片2

名称:图2
描述:幻灯片3

名称:图3
描述:幻灯片4

名称:图4
描述:幻灯片5

名称:图5
描述:幻灯片6

名称:图6
描述:幻灯片7

名称:图7
描述:幻灯片8

名称:图8
描述:幻灯片9

名称:图9
描述:幻灯片10

名称:图10
描述:幻灯片11
名称:图11
描述:幻灯片12
名称:图12
描述:幻灯片13
标签:

- 许春雷
×参考诊断













